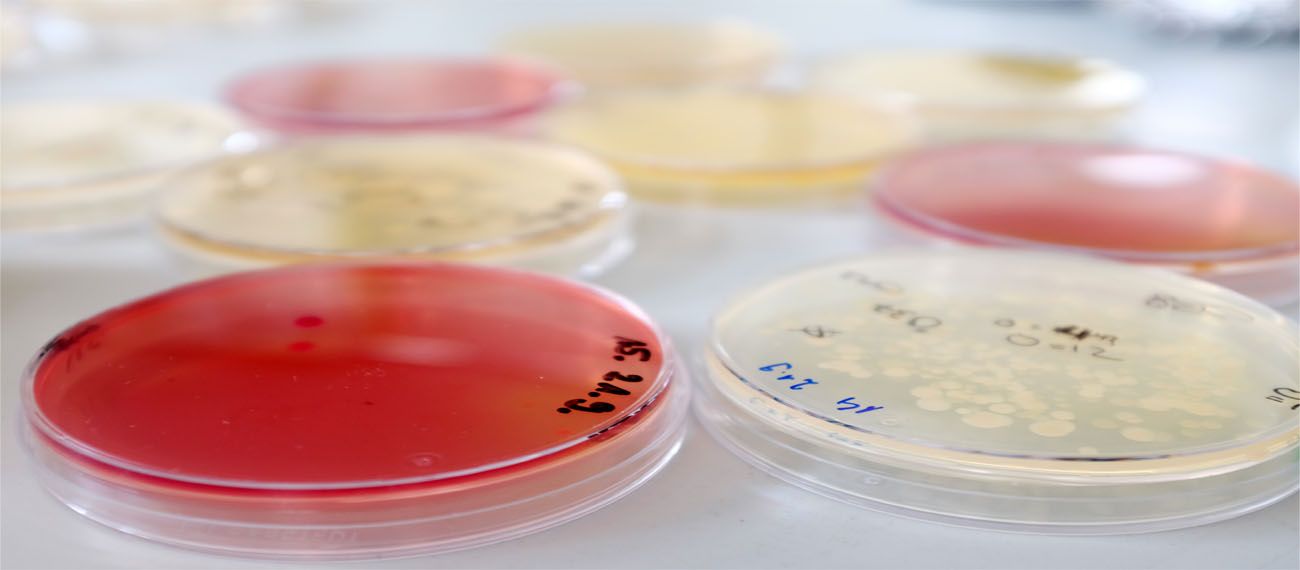

Schleswig-Holstein
Schleswig-Holstein is the northernmost region of Germany. Its RIS3 identifies maritime economy as one of its five fields of specialisation.
The region in brief
Schleswig-Holstein is the northernmost of the 16 German states. “Germany’s True North” clearly benefits from its location: It is bordered by Denmark in the north, the metropolitan area of Hamburg in the south and framed by the Baltic Sea to the east and the North Sea to the west.
Schleswig-Holstein is home to some 2.9 million inhabitants and spans an area of almost 15,800 km2. Its population density of 182 inhabitants per km2 lies a little below the German average. Besides minority groups of Danes, Frisians, Sinti and Roma, almost 15% of Schleswig-Holstein’s population have a migration background.
The state’s capital Kiel is also its largest city, followed by Lübeck and Flensburg. All three are situated on the Baltic coast and are harbour cities. Kiel and Lübeck are important cruising destinations and run ferry connections to Norway, Sweden, Finland, Lithuania and Latvia.
Due not only to its position between two seas with yellow sand beaches, but also because of its green landscape and numerous blue lakes, Schleswig-Holstein belongs to Germany’s most visited touristic regions. It also boasts a vibrant and diverse cultural scene with well-known museums (e.g. in the old city of Lübeck or Gottorf castle near Schleswig), the homes of famous writers like Thomas Mann or Günther Grass and internationally renowned music festivals such as Schleswig-Holstein Music Festival, Folk Baltica or Jazz Baltica.
The blue economy in Schleswig-Holstein today
For centuries, Germany’s north has been an agricultural region. This started to change in the 20th Century with the advent of sectors such as food processing, mechanical engineering, maritime industries, life sciences und information technologies. Schleswig-Holstein’s modern economy is characterised not by big names but by the numerous mid-sized companies that are nonetheless global players in their respective fields.
In 2017, Schleswig-Holstein had a gross domestic product (GDP) of € 93.4 billion in total, or around € 66,664 per employee. This is well above the European average but lies at only 90% of Germany’s overall GDP. To narrow this gap, the government of Schleswig-Holstein is increasingly focused on concepts for innovation.
The RIS3 analysis identified five fields of specialisation based on key technologies and cluster structures:
- Maritime Economy,
- Life Sciences,
- Renewable Energies,
- Food Sector,
- Information Technologies, Telecommunication, Media.
In the maritime sector, Schleswig-Holstein has 1,800 companies, 42,000 employees and an annual turnover of € 9.2 billion. The core of the maritime economy consists of ship building companies together with their supply industries. Other important segments are maritime logistics (shipping, ports, the Kiel canal), boat and yacht building, and – fast growing – offshore and underwater technologies, marine research, fisheries and aquaculture as well as hydrographic and other maritime services.
The maritime cluster is distinctly knowledge and technology driven: it is based on own research and technology absorption. Two thirds of the maritime companies see themselves as technology producers, one third as technology users.
Schleswig-Holstein hosts a very developed and differentiated marine and coastal science and research landscape, which includes the Maritime Centre of the Universities of Applied Sciences in Kiel and Flensburg, the Helmholtz Centre Geesthacht (Institute for Materials and Coastal Research), the Helmholtz Centre for Ocean Research GEOMAR in Kiel, the Excellence Cluster “Future Ocean” at Kiel University and island posts of the Alfred Wegener Institute for Ocean and Polar Research on Helgoland and Sylt. A particular strength of Schleswig-Holstein is the broad base in marine research (e.g. marine research technologies, hydrography) and in marine biotechnology.
Due to cross innovation, the four other fields of specialisation are closely related to the maritime economy. For example, the following sectors are connected:
- Marine aquaculture and food industry,
- Information technologies and equipment on modern vessels,
- Marine biotechnologies and life sciences,
- Renewable energies from the sea.
Therefore all the focus areas are more or less related to blue growth and contribute to maritime applications.
The blue economy of tomorrow in Schleswig-Holstein – our vision
The various integration opportunities within the maritime cluster and the interfaces between the sectors of the maritime industry and related technology sectors offer numerous growth paths for the future in Schleswig-Holstein. These are located mainly in the sector of maritime and marine technologies (for example, deep-sea exploration), in special vessels, in offshore energy (wind, oil, gas) and in the field of marine biotechnology.
Relevant development potential is also expected for the ports in Brunsbüttel, Kiel, Lübeck and Rendsburg as assembly and production facilities of the maritime industry as well as for the island of Helgoland as a base for the installation, supply and maintenance of wind farms. Therefore a modern port infrastructure with available hinterland areas for the settlement of high-tech firms is especially important to lead industry into the orbit of offshore wind parks.
Especially in the context of the major global challenges of the future such as climate change, resource scarcity and sustainability, health and nutrition, the maritime economy offers numerous applications and favourable conditions for setting up cross innovations. On one hand, it promotes the development of alternative resources and energy, whilst on the other making an important contribution to the health and food industries (e.g. through aquaculture for use in the food and pharmaceutical industries).
For sustainable development, maritime technologies accompanied by marine and coastal science and research in Schleswig-Holstein play a strategic role, for instance in the development of a market of energy and raw material resources from the sea. This is highly relevant not only for the cluster maritime economy but also for the clusters of renewable energies, tourism and the food industry.
Sooner or later, climate change and the scarcity of oil and gas will mean the end of the global carbon-based economy. Schleswig-Holstein, with its focus on renewables and the bioeconomy, is in a good position to do well and develop in this new era. It is an approach that needs to be followed consistently, especially in the maritime fields of offshore energies, aquaculture and marine biotechnology, to create “blue” growth.
Transnational cooperation interests in blue growth:
General interest exists in the field of maritime technology and more specifically in marine mining. In the field of shipbuilding, most interest has been shown regarding green shipping (LNG, exhaust gas treatment, scrubbing etc.), energy efficiency (hull shape, streamlining of the fuselage, propeller shapes), individual shipbuilding and optimisation by adapting shape and function to the usage of the ship as well as digitalisation and autonomous shipping. In the offshore wind technology sector, the focus of interest is in reducing costs in construction and installation as well as in monitoring devices for the detection and surveillance of damages. Furthermore there is interest in transnational cooperation concerning the issue of blue biotechnology in food industry (food security, legal aspects) and health issues. Moreover, interest in the field of aquaculture has been raised concerning the efficient use of material flows (circular economy). Last but not least a need for better knowledge exchange and cooperation between the sectors of blue biotechnology, aquaculture, energy, technology and machinery has been mentioned by the blue growth actors in Schleswig-Holstein.



